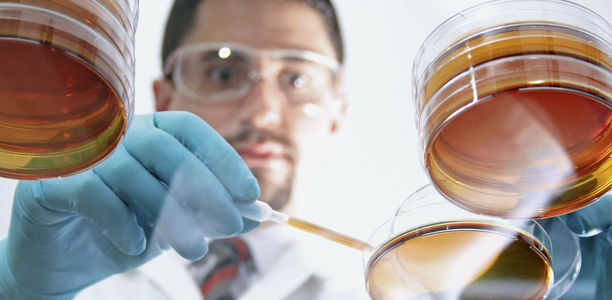
Bild zu Typ-2-Diabetes - Forscher entdecken neue Wirkstoffklasse

Ein US-amerikanisches Wissenschaftlerteam berichten in einer Forschungsarbeit über eine neue Substanz, die sich für die Behandlung des Typ-2-Diabetes eignen könnte. Sie unterbindet die Bildung von Zucker in der Leber, verbessert den Stoffwechsel und die Insulinwirkung – bisher allerdings nur im Tiermodell.
Ist die sogenannte Basistherapie bei Typ-2-Diabetes nicht erfolgreich, kommen verschiedene Diabetesmedikamente zum Einsatz. Sie sollen eine Gewichtsabnahme und eine Blutzuckersenkung erreichen. Für bessere Ergebnisse und mehr Möglichkeiten, die Therapie auf den einzelnen Patienten anzupassen, suchen Forscher weltweit nach neuen Behandlungsstrategien. Eine Gruppe aus den USA könnte nun ein neues Werkzeug gefunden haben.
350.000 verschiedene Substanzen wurden insgesamt getestet
Dafür konzentrierten sie sich auf das Molekül PGC-1a: Es steuert die Bildung von Zucker (Glukose) in der Leber und beeinflusst den Energiehaushalt. Diese Eigenschaften machen es zu einer sehr geeigneten Zielstruktur für Diabetesmedikamente. Allerdings galt PGC-1a, den Autoren zufolge, bisher als non-druggable, also nicht durch Medikamente beeinflussbar.
Um dieser Annahme auf den Grund zu gehen, entwarfen sie ein groß angelegtes Suchverfahren nach möglichen Wirkstoffen, ein sogenanntes Hochdurchsatz-Screening. Damit testeten sie rund 350.000 verschiedene Substanzen hinsichtlich ihres Einflusses auf PGC-1a. Dabei kristallisierten sich weit über 700 Kandidaten heraus. In weiteren Versuchen testeten die Wissenschaftler diese umfangreich auf gute Wirksamkeit und Verträglichkeit, sodass sich die Liste auf neun mögliche Verbindungen reduzierte.
Im Tiermodell verbesserten sich Nüchternblutzucker und Insulinsensitivität
Den vielversprechendsten Kandidaten (eine Substanz mit dem Namen SR-18292) testeten die Forscher dann zunächst an menschlichen Leberzellen und in der Folge auch an Mäusen mit Typ-2-Diabetes. Dabei beobachteten sie, dass die Gabe des Wirkstoffs die Aktivität von PGC-1a bremste. In der Folge verbesserten sich bei den Tieren der Nüchternblutzucker sowie die Insulinsensitivität.
Letzteres bezeichnet die Empfindlichkeit des Körpers gegenüber Insulin, also wie gut das Hormon den Blutzucker kontrollieren kann. Entsprechend verbesserte sich bei den Versuchstieren auch der Zuckerstoffwechsel durch die Testsubstanz. Wie von den Forschern vermutet, gingen die Effekte auf eine geringere Zuckerproduktion in der Leber zurück.
Die Publikation im renommierten Fachjournal Cell spricht dafür, dass die Fachwelt die neue Wirkstoffklasse für relevant hält. Nach eigenen Angaben wissen die Forscher bisher allerdings noch nicht konkret, durch welchen Mechanismus die Testsubstanz genau auf PGC-1a wirkt. Zudem müssten künftige Studien noch beweisen, dass auch menschliche Diabetespatienten gefahrlos davon profitieren können. Entsprechend viel Arbeit und Zeit müsste noch investiert werden.